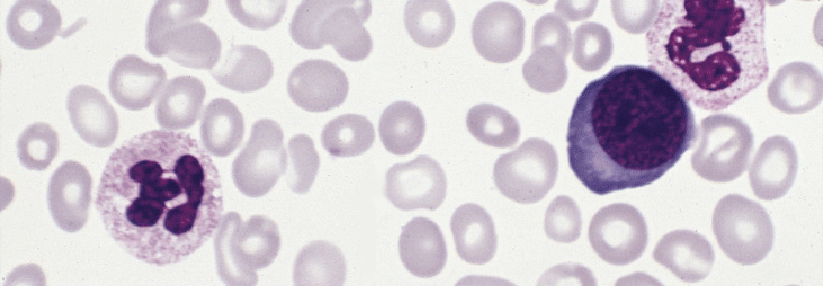

Thrombophilie: Grundlagen der Anamnese und Diagnostik
 Die Differenzierung zwischen provozierten und nichtprovozierten VTE ist wichtig für die Therapiedauer.
© iStock/Dr_Microbe
Die Differenzierung zwischen provozierten und nichtprovozierten VTE ist wichtig für die Therapiedauer.
© iStock/Dr_Microbe
Die Definition ist klar: Patienten mit Thrombophilie neigen zur Bildung von Blutgerinnseln. Dabei kann das arterielle System ebenso betroffen sein wie das venöse. Typisch für diese Erkrankungen ist ein gestörtes Gleichgewicht zwischen pro- und antikoagulatorischen Einflüssen. Zur Abklärung eignet sich eine Kombination von Eigen- und Familienanamnese mit klinischer Untersuchung und gezielter Labordiagnostik.
Achtung, Überdiagnostik!
Bei diesen Personen sollte man die Thrombophiliediagnostik sein lassen:
- Patienten mit Tumoren (aktiv oder anamnestisch)
- Patienten mit Venenthrombose/Lungenembolie, posttraumatisch und/oder postoperativ
- Patienten im Alter > 60 Jahre
- Patienten im Alter > 50 Jahre mit mindestens einem Risikofaktor für VTE
- Verwandte 1. und 2. Grades mit VTE im Alter > 60 Jahre n Patienten ohne Nachkommen und Geschwister
- Patienten in der Akutphase der VTE
- Frauen mit negativer persönlicher oder familiärer Anamnese vor Verordnung der Pille
Nur in Einzelfällen nach hereditären Ursachen suchen
Das Risiko für venöse Thromboembolien (VTE) wird maßgeblich durch angeborene und/oder erworbene Faktoren bestimmt. Wichtig für die Therapiedauer ist die Differenzierung zwischen provozierten und nicht-provozierten VTE. Hereditäre Thrombophilien werden am häufigsten durch einen Mangel an natürlichen antikoagulatorischen Proteinen wie Antithrombin, Protein C oder Protein S ausgelöst. Diese Defekte erhöhen vor allem das Risiko für die erste Thrombose, für Rezidive dagegen kaum, erläutern Privatdozent Dr. Giuseppe Colucci und Professor Dr. Dimitrios A. Tsakiris vom Universitätsspital Basel. Arterielle Thrombophilien werden meist durch klassische atherogene Risikofaktoren wie arterielle Hypertonie, Dyslipidämie und Diabetes gefördert. Auch Malignome und östrogenhaltige Medikamente spielen eine wichtige Rolle, während angeborene Störungen nur einen geringen Einfluss haben. Bei jedem Patienten sollte nach klinischen Zeichen einer erworbenen Thrombophilie geschaut werden. Ein labordiagnostischer Ausschluss hereditärer Ursachen dagegen ist nur bei gut begründeter Indikation angezeigt, das heißt, wenn der Patient eines der folgenden Ereignisse erlebt hat:- idiopathische Thromboembolie bei Patienten < 50 Jahre
- rezidivierende Thromboembolien
- unklare rezidivierende Aborte
- Thromboembolien unter östrogenhaltigen Medikamenten
- atypisch lokalisierte Thrombosen (Arm, Pfortader, Mesenterium)
- gekreuzte arteriovenöse Thrombosen bei offenem Foramen ovale
- Frauen vor Verschreibung der Pille bei VTE-Risiko (persönlich oder familienanamnestisch)
Oft liefert schon das Blutbild wichtige Hinweise
Wenn möglich, sollte zunächst der Patient mit der Thromboembolie weiter untersucht werden. Bei seinen Verwandten fahndet man dann gezielt nach dem ermittelten Defekt. Kann der Index-Patient nicht untersucht werden, forscht man bei einem Verwandten mit positiver Familienanamnese (z.B. VTE bei Verwandten ersten oder zweiten Grades) nach. Häufig gibt schon das Blutbild wichtige Hinweise auf eine Krankheit mit erhöhtem Thromboserisiko. Vor allem bei jungen Menschen mit atypisch lokalisierter oder ausgedehnter VTE sollten myeloproliferative Neoplasien wie Polycythaemia vera und essenzielle Thrombozythämie ausgeschlossen werden. Für zuverlässige Ergebnisse sollte die Thrombophilie-Diagnostik erst einen Monat nach dem Ende der Antikoagulation erfolgen, unter einer Langzeitkoagulation frühestens zwei bis drei Monate nach dem akuten Ereignis.Was wird untersucht?
Gerinnungsstatus (Quick/INR), aPTT, Fibrinogen, D-Dimere, Protein C funktionell, Protein S funktionell, Antithrombin funktionell, APC-Resistenz, Autoantikörper gegen Beta-2-Glykoprotein I und Antikardiolipin (jeweils IgG und IgM), Lupus-Antikoagulans. Die genetische Untersuchung umfasst unter anderem die Suche nach der Faktor-V-Leiden-Mutation.
Ein wichtiges Ziel der Thrombophilie-Diagnostik ist, Kandidaten für eine dauerhafte Antikoagulation zu identifizieren. Außerdem gilt es, Verwandte aufzuspüren, denen das Meiden von Risikofaktoren oder eine medikamentöse VTE-Prophylaxe nützen könnten. Dabei lohnt ein Blick auf das Risiko: Die Thrombosewahrscheinlichkeit bei adipösen Männern über 60 Jahre ist fünffach erhöht, Personen mit Lupus-Antikoagulans leben mit einem fünf- bis achtfachen Risiko für unerwünschte Gerinnsel. Bei einem Antithrombinmangel verdoppelt sich die Gefahr, Patienten mit Faktor-V-Leiden-Mutation haben zwei- bis dreimal mehr VTE als Gesunde.
Quelle: Colucci G, Tsakiris DA. Swiss Med Forum 2020; 20: 73-78; DOI: 10.4414/smf.2020.08452






